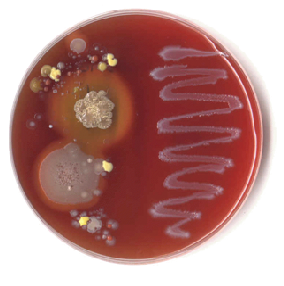

Agar Sangre de Cordero (Base Columbia)
Descripción General y Aplicaciones Críticas
El Agar Sangre de Cordero con base Columbia es un medio de cultivo altamente nutritivo, diseñado para la detección de la actividad hemolítica en una amplia variedad de microorganismos patógenos.
Su fórmula enriquecida permite el crecimiento de especies tanto exigentes como no exigentes, superando la capacidad del agar sangre con base clásica. Esto lo convierte en el medio de elección en entornos donde se requiere el aislamiento de microorganismos con requerimientos nutricionales complejos.
Aplicaciones Fundamentales:
- Detección de Hemólisis: Visualización precisa de los halos de hemólisis $(\alpha, \beta, \gamma)$ para la identificación de especies bacterianas.
- Aislamiento y Confirmación: Ideal para patógenos clave como Listeria monocytogenes, Clostridium perfringens, Bacillus cereus, y Legionella pneumophila.
- Entornos Clínicos: Su riqueza nutritiva lo hace indispensable para el aislamiento de microorganismos en ambientes frecuentados por personas enfermas o inmunodeprimidas (hospitales, quirófanos, UVIs).
Composición de Calidad Superior al Agar Sangre típico
La formulación Columbia se caracteriza por la variedad de peptonas que ofrecen un suministro óptimo de nitrógeno, aminoácidos y péptidos de cadena larga, garantizando un crecimiento robusto.
El medio una vez preparado incluye 5 mL de sangre desfibrinada de cordero por cada 100 mL, para observar claramente las reacciones de hemólisis.
| Componente | Cantidad por Litro (g) |
| Peptona de Caseína | 10 g |
| Peptona de Carne | 5 g |
| Extracto de Levadura | 3 g |
| Extracto de Corazón | 3 g |
| Cloruro Sódico | 5 g |
| Almidón de Maíz | 1 g |
| Agar Bacteriológico | 15 g |
| Sangre de Cordero | 50 mL |
Fórmula por Litro: pH 7.2 +/- 0.2
Control de Calidad y Crecimiento
Garantizamos un estricto control de calidad en nuestras instalaciones. Le recomendamos encarecidamente repetir estas pruebas si observa cambios en las condiciones de almacenamiento (ej. más de 3 meses sin usar, fluctuaciones de temperatura).
- Estado Deshidratado: Polvo, color Beige.
- Estado Preparado (Placa): Estéril, color Rojo Cereza por la sangre.
Control de Crecimiento Cuantitativo (48 horas a $\mathbf{37 °C}$):
| Cepa de Referencia (MKTA) | Resultado de Crecimiento | Actividad Hemolítica |
| Clostridium sporogenes 11437 | Crecimiento Correcto (crecimiento > 50% con inoculación < 100 ufc) | – |
| Streptococcus viridans | Crecimiento Excelente | alpha-Hemolítico |
| Listeria monocytogenes 7644 | Buen Crecimiento | beta-Hemolítico |
| Enterococcus faecalis 29212 | Buen Crecimiento | gamma-Hemolítico (No hemolítico) |
Siembra e Interpretación de Resultados
Para obtener resultados óptimos, asegúrese de que las placas hayan alcanzado la temperatura ambiente y presenten una superficie húmeda, pero sin condensación excesiva.
1. Métodos de Siembra
- Análisis de Muestras: ESTRÍE la muestra diluida o enriquecida en la superficie de la placa hasta obtener colonias aisladas por agotamiento.
- Análisis Cualitativos de Aire: Deje las placas abiertas en los puntos de muestreo críticos durante 10 a 30 minutos.
- Análisis Cuantitativos de Aire (Recomendación profesional): Utilice un muestreador tipo Microflow con cabezal para placas Petri de $\text{90 mm}$.
- Mantenga el flujo de aire perpendicular a la superficie del medio.
- Se recomienda analizar $\text{200 L}$ de aire a un caudal de $\text{0.5 L/seg}$ para máxima recuperación.
- Cálculo: Multiplique el recuento de colonias en la placa por 5 para obtener el recuento total por metro cúbico. Para ambientes limpios, sume los resultados de 5 muestras de $\text{200 L}$ para obtener el recuento por metro cúbico.
2. Incubación y Lectura
- Condiciones: La incubación estándar es en atmósfera aerobia a la temperatura óptima de crecimiento del microorganismo buscado o, por defecto, a $\text{37 °C}$ (aprox.).
- Nota: Ciertas especies, como Campylobacter spp., requieren una atmósfera enriquecida con 5-10% de $\text{CO}_2$.
- Tiempos: La lectura debe realizarse entre las $\mathbf{18}$ y $\mathbf{48}$ horas. Las reacciones de hemólisis se aprecian mejor entre las $\mathbf{18}$ y $\mathbf{24}$ horas.
Es fundamental que las reacciones hemolíticas y el aspecto de las colonias (ej. umbilicación en neumococo) se ajusten a las descripciones típicas para una identificación certera.
Información de Producto
- Presentación: Dada la inestabilidad de la sangre, este medio completo solo está disponible en placa preparada.
- Para Uso Exclusivo en Laboratorio.
- Conservación: Las placas preparadas deben conservarse en refrigeración (entre 4 y 15 °C y manipularse con cuidado para evitar choques térmicos. Respete rigurosamente la fecha de caducidad.
- Código de Producto: PPLS01
- Medio Deshidratado (Base Columbia): Consulte la referencia DMT308.
CONSULTAS
Para consultas y precios actualizados sobre AGAR SANGRE DE CORDERO o cualquiera de nuestros productos no dude en ponerse en contacto con nosotros a través del teléfono 91-897 46 16 o el correo electrónico microkit@microkit.es.
https://www.microkit.es/fichas/BLOOD-AGAR-BASE.pd
Tambien en placas preparadas con la sangre ya añadida:
https://www.microkit.es/fichas/BLOOD-AGAR-SHEEP-PREPARADO.pdf

cual es el medio de cultivo para bartonela
Buenos días
Respondemos a su consulta desde nuestro correo general.
Muchas gracias por visitar nuestro blog y contactar con nosotros. Un cordial saludo.
por favor cotizar placas de agar sangre y el tiempo de vencimiento de las mismas
Buenos días
Respondemos a su consulta desde nuestro correo general.
Muchas gracias por visitar nuestro blog y contactar con nosotros. Un cordial saludo
Buenos días:
Trabajo en Laboratorio Público y quería saber vuestra opinión sobre cual es más efectivo o si son iguales ,para emplear en análisis de aire, en el control medioambiental, el agar sangre de cordero o el agar sangre de caballo??.
Buenos días
Respondemos a su consulta desde nuestro correo general.
Muchas gracias por visitar nuestro blog y contactar con nosotros. Un cordial saludo
Buenos días
Espero me puedan responder a esta pregunta de investigación para un trabajo de la universidad
Tienen conocimiento sobre la composición química de los nombres a continuación:
Agar nutritivo (Miuller Hilton)
Agar base sangre agar (Macconkey)
Agar-Manitol-Sal-Agar
Se podria usar este medio de cultivo para aislar Cutibacterium acnes?
Buenos días,
Respondemos su consulta desde nuestro correo general. Muchas gracias por visitar nuestro blog y contactar con nosotros.
Un cordial saludo
Buenas, tengo una duda sobre un trabajo de mi universidad; seria muy útil su ayuda. ¿Cuál es el fin de los nutrientes que forman el agar sangre de cordero?
Que crezca todo tipo de patógenos, la sangre además los distingue según sea su hemólisis